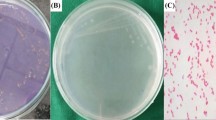

Abstract
Background
The current study was conducted to find out an eco-friendly and cost-efficient way to prepare copper nanoparticles (CuNPs) by utilizing Grewia asiatica L. leaf extract, which was found to be a very effective antimicrobial and larvicidal chemical.
Methods
Characterization of nanoparticles was also carried out by utilizing Fourier transform infrared spectroscopy (FTIR) analysis, scanning electron microscope along with X-ray diffraction analysis (XRD). The artificially prepared nanoparticles in the laboratory were approximately in the range of 2 µm in size and crystalline in nature. The CuNPs were tested for their antimicrobial activity against different types of fungi and bacteria, also some mosquito and termite. All the results and observations were tested with a one-way analysis of variance keeping the probability level at < 0.0001.
Results
The copper nanoparticles exhibit significant antibacterial and antifungal activities and are also found lethal for many mosquito and termite species. Antibacterial activity was checked against Escherichia coli and Bacillus subtilis, their zone of inhibition was 17 nm and 20 nm, respectively. The antifungal potential was checked against Aspergillus niger and Aspergillus oryzae and the zone of inhibition was recorded at 20 mm and 23 mm, respectively. CuNPs were also found lethal for many mosquitoes and maximum efficacy of CuNPs against Aedes aegypti larva was observed at 100 mg/ml after 24 h. Termite species such as Heterotermes indicola were exposed to CuNPs and the highest mortality rate in termites was seen at 100 ppm concentration of CuNPs. Current research provides the first investigation of CuNPs of G. asiatica as a larvicidal and as an anti-termite. G. asiatica garden-fresh leaves were collected from Railway colony Mughalpura.
Conclusions
This study proves that CuNPs have a toxic effect on insects and can also be utilized as a biological control of insects. By using such a scientific approach, the scientists can lower the costs of chemical usage and a biodegradable alternative could be provided.
Similar content being viewed by others
Background
The plants serve as a natural remedy for human suffering, especially in mountainous regions. In the field of medicine, traditional plants play a key role in being a kind of backbone towards its advancement, all due to their magnificent chemical constituents. Pakistan is one of the richest countries over the globe in terms of versatility in its climatic conditions, elevation and vegetation, where, almost 700 species of plants are being used to treat ailments and aesthetic purposes which are found in the Himalayan regions. A variety of plant sections are useful for the treatment of a wide range of ailments but leaves are at the top because of their easy accessibility, and rich secondary metabolites, also, they can be used alone or with other plant parts (Aziz et al. 2017). A significant member of the family Tiliaceae is Grewia asiatica L., locally known as Phalsa in Pakistan, which is found scattered in the Himalayas up to 3000 ft in height. In the province of Punjab, it is likewise economically developed (Paul 2015). Different plant organic parts such as leaves, stems and others are used for different remedial purposes. The plant contains certain compounds which are anticancer, hepatoprotective, antidiabetic, antifertility, antihyperglycaemic, radioprotective, antiviral, antimicrobial, antifungal, pain-relieving and antipyretic (Sinha et al. 2015). The use of nanotechnology in drugs and its delivery is spreading quickly. At present, numerous substances need to explore that are responsible for drug delivery and cancer treatment. A significant role is played by herbal medicines in pharmacopoeia and nano-formulations by using nanotechnology, advancement in this regard has taken place. Herbal products have been turned into a useful remedial solution for a livelihood because of their benefits with no side (Ahmed et al. 2016).
The major contributing elements to an unnatural weather change and environmental changes are the toxins and pollutants produced from various physical and synthetic procedures. A global complaint about mindfulness and awareness to diminish these pollutants was incited by this troubling condition. Subsequently, green chemistry is progressively integrated into science and industry. There is a high need to include eco-friendly methods that do not use harmful ingredients during their production. Metal-based nanoparticles are currently widely utilized by humans in different processes. An alternative method for nanoparticle synthesis is a natural technique which utilizes natural products. While the inorganic nanoparticles produced by the natural method are highly biocompatible and ecofriendly (Singh et al. 2016).
For the nanoparticle’s synthesis, numerous organisms have been used. In the previous studies significant examinations have been carried out on the synthesis of nanoparticles and their action against harmful microorganisms (Caroling et al. 2015a; Chandrakant et al. 2013) yet not much research was carried out on the anti-larvicidal and termite potential of CuNPs. Plant-based NPs are highly stable and their synthesis is progressively quick as compared to nanoparticles synthesized by bacteria and fungi (Singh et al. 2016).
Among the nanoparticles, copper nanoparticles drag attention due to their optical, catalytic, non-toxicity, antibacterial, antifungal and high conductivity properties. They are also significant due to their cost-effectiveness and potential heat transfer properties. Copper nanoparticles can be synthesized easily and modified into the required size, shape and dimensions. Their biological activities are also noticeable, making them a useful source for antibiotics production (Akintelu et al. 2021).
Grewia asiatica L. is widely distributed in South Asian countries and is important as an edible fruit and also a medicinal plant. Its fruits contain nutrients i.e., vitamins, minerals, proteins, and certain phytochemicals i.e., flavonoids, tannins, anthocyanins and phenolics. The plant also possesses many therapeutic properties. Plant leaves possess anticancer, antiemetic, antimicrobial, and antiplatelet properties and stem bark contains anti-inflammatory properties (Zia-Ul-Haq et al. 2013).
The microorganisms are the main reason for skin and gastrointestinal ailments in Pakistan and there are few researches carried out on revealing how the indigenous plant species act as an antimicrobial agent. Therefore, the current investigation possesses much impulsion and it will provide valuable data about the utilization of G. asiatica (Common name: Phalsa) for its therapeutic properties which is a cheaper method for nanoparticle synthesis and environment friendly as compared to other methods. The objectives of this study are to synthesize and characterize copper nanoparticles from leaves extract of G. asiatica and assessing their biological activities such as antibacterial, antifungal, larvicidal and anti-termite activities.
Methods
-
Materials
Distilled water, potato dextrose agar, hydrochloric acid (HCl), ethanol (> 99%), copper sulfate (CuSO4.5H2O), and nutrient agar.
-
Glassware and equipment
Petri dishes, conical flask, Plastic bottles with cap, Beakers, stirrer, test tubes with caps, aluminum foil funnel, filter papers, sprite lamp, wire loop, mechanical spreader, round bottom flask soxhlet extractor, water bath, Physical balance, shaking incubator (Sanyo Gallen Kamp, UK), rotary evaporator, laminar airflow (Technico scientific supply, Lahore), autoclave (HVA 101, Japan), centrifuge (Sigma 2–6, USA), incubator (EHRET-BK4444, Germany), UV–visible spectrophotometer (Nicolet 300 Thermo the USA), FTIR, XRD.
-
Organisms
Bacteria, Fungi, Nematodes, Mosquito larvae.
Collection of samples
For the collection of plants different local sites in Lahore, Pakistan was selected. The preference was to collect garden-fresh leaves from Railway colony Mughalpura, Manawa and Harbanspura canal bank road, Multan road and Jail road right in front of Lahore College for Women University.
Grewia asiatica L. leaves extract preparation
Plant leaves were dried and crushed into fine powder. The aqueous extract of plant leaves was obtained by using the Soxhlet extractor for distilled water was heated at 100 °C for eight hours, and then the solvent was evaporated using a rotary evaporator yielding a gummy mass of plant in the flask (Zia-Ul-Haq et al. 2014).
Biosynthesis of Grewia asiatica L. leaves extract-based copper nanoparticles
To biosynthesize the CuNPs of Grewia asatica L. the 1.0 mM aqueous solution of copper sulfate (CuSO4.5H2O) was prepared, and 90 ml of Copper sulfate solutions were added with 10 ml leaves extract of the selected plant. The solution was warmed using a water bath for 60 min at 70 °C. After warming, the solution was then incubated in a shaking incubator for 24 h at the speed of 140 rpm. There was a color change in the solution after incubation. On the other hand, a control setup was likewise held by mixing distilled water in the plant extract. Finally, the solution containing Cu-based nanoparticles was centrifuged at 10,000 rpm for about 20 min. Then the obtained pellets were dispersed in the distilled water, after washing them thoroughly (Saranyaadevi et al. 2014).
The copper-based nanoparticles characterization
Following protocols were adopted for the characterization of the biosynthesized nanoparticles.
Ultraviolet–visible spectroscopy analysis
The CuNPs were formed when copper sulfate was reduced which was observed via UV–visible spectrophotometer (Perkin Elmer Lambda 950) and the scanning was done in a defined range of 200–600 nm (Ramyadevi et al. 2012).
The FT-IR spectroscopy
Multiple times centrifuged pallets were subjected to FTIR (Midac MC 2000 Spectrometer) where the FTIR spectrum was examined in a range of 6000–300 cm−1 wavelength interval for the CuNPs and leaves extract both (Umer et al. 2014).
The X-ray diffraction analysis
The dried sample of the prepared NPs was analyzed by X-ray diffraction on an XRD machine [XRD-D8 Discover, Bruker, Germany]. The scanning of the sample took place in a range of 2θ where the angle was from 10° to 80° (Zhu et al. 2004). The XRD value of the reflection pattern was according to file No. 04-0838, for Copper as suggested by JCPDS. Whereas the Debye- Scherrer equation was used to compute the size of the particles.
The scanning electron microscope analysis
JSM-6480 scanning electron microscope (SEM). Very clear and fine images of CuNPs were obtained by SEM analysis in terms of their size and shape (Jayandran et al. 2015).
Testing of the copper nanoparticles for their biological activities
The G. asiatica L. leaves extract-based nanoparticles were analyzed for their antimicrobial activity against certain microorganisms such as Bacteria, Fungi, Larvae and Termites. Two strains of bacteria including Escherichia coli and Bacillus subtilis along with two different parasitic species of fungi including Aspergillus niger and Aspergillus oryzae, were chosen. The standard agar-well diffusion method was utilized and the culture plates were incubated for almost 24 h at 37 °C. The zone of inhibition was measured after the incubation period and the Minimum Inhibitory Concentration test was performed for bacterial species (Kaneria et al. 2009).
Anti-bacterial activity
Two pathogenic bacterial strains were selected i.e., E. coli LCWU 009, B. subtilis LCWU HI93 and the agar-well diffusion method was used. Four wells were made in a nutrient agar medium using gel puncture under aseptic conditions. Then 30 µl of CuNPs solution was added to well 1 and G. asiatica L. leaves extract in well 2. Distilled water and streptomycin were used as control in well 3 and 4, respectively. The plates were then incubated for 24 h at 37 °C. The diameter of the f zone of inhibition was measured after incubation (Saranyaadevi et al. 2014; Ramyadevi et al. 2012).
MIC of bacterial species
For the measurement of minimum inhibitory concentration agar diffusion method was used. The concentration of extract and nanoparticles (1 mg/ml, 2 mg/ml, 3 mg/ml, 4 mg/ml, 5 mg/ml, 6 mg/ml, 7 mg/ml, 8 mg/ml and 9 mg/ml) was prepared. Each test tube was inoculated with bacterial species. A control was set up for bacterial growth in no condition. The samples were incubated for 24 h at 37 °C. After incubation small amount from each test tube was streaked on the petri plates containing nutrient agar. These petri plates were incubated at 37 °C for 24 h. After 24 h of incubation bacterial colonies were counted in each petri plate (Umer et al. 2014).
Anti-fungal activity
Agar well diffusion method was employed to evaluate the anti-fungal activity against two pathogenic fungal strains i.e., A. niger LCWU 045, A. oryzae LCWU 760. Four wells were made in agar medium using gel puncture under aseptic conditions. Then 10 µl of CuNPs solution was added in the well 1 and G. asiatica L. leaves extract in well 2 under aseptic conditions. Distilled water and streptomycin were used as control in well 3 and 4, respectively. The plates were then incubated for 24 h at 35 °C. The zone of inhibition was observed after incubation (Zhu et al. 2004).
The larvicidal action
For the testing of the selected plant’s larvicidal activity a mosquito specie called Aedes aegypti were taken. After 4 days of hatching mosquito larvae enter into early fourth larval stage and experiment was conducted. Twenty larvae were exposed to 100 ml of each test concentration (20 mg/ml, 40 mg/ml, 60 mg/ml, 80 mg/ml and 100 mg/ml). While the control set was kept without CuNPs to observe the normal death rate. Deltamethrin an ordinary insect killer was used for positive control. The samples were incubated in shaking incubator at 30 °C and 15 rpm, to ensure the sufficient supply of oxygen to larvae. Larvae death rate was observed after specific time duration (Jayaseelan et al. 2012).
The anti-termite action
H. indicola is a specie of termites that was selected for evaluation. In the experiment the filter papers were treated with prepared solutions and the filter paper used as control was kept untreated. On each petri plate fifty active termites of H. indicola were introduced. Periodically, water droplets were added in the petri plates to keep the filter paper wet. These petri plates were kept in an incubator at 26 °C temperature in darkness. The weight of filter papers before and after treatments were recorded, and the mortality rate of termites was checked for 8 weeks with every 24 h interval (Angrasan and Subbaiya 2014).
The statistical analysis
One-way analysis of variance (ANOVA) (single factor) was applied along the groups to detect the variance with keeping the probability as P < 0.0001.
Results
From the literature, it is very clear that almost every section of the Angiosperms can be used to biosynthesize nanoparticles (Valli and Suganya 2016). In the present experiments, brown-colored and fine nanoparticles were synthesized by centrifugation followed by re-dispersing the pallets in the double-distilled water.
The characterization of biosynthesized copper-based nanoparticles
The ultraviolet–visible spectroscopy
A maximum absorbance range of 300–350 nm was observed for the laboratory-prepared CuNPs. A prominent difference was observed between two UV–visible spectrums, before and after the reaction between leaves extract and copper salt, where this is comparable to the values in the literature (Valli and Suganya 2016; Karimi and Mohsenzadeh 2013).
The FT-IR spectroscopy
FT-IR spectroscopy analysis was performed against the G. asiatica leaves extract to assess its reducing, capping and stabilization. The FT-IR spectra of leave showed peaks at 1032.08, 1335.37, 1371.50, 1459.10, 1596.89 and 2100.96 (Fig. 1). These peak values reveal, aliphatic amines (C–N) stretch in the ring, aromatic amines (C–N) stretch, alkyl halide (C–H), alkane (C–H) bend, aromatics (C–C) stretch, alkyne (–C≡C– stretch), functional groups which play a significant role in nanoparticles biosynthesis. FT-IR spectra of plant-based CuNPs represent complying with the reference plant. The peak values showed that copper nanoparticles may be encompassed by these functional groups (Fig. 2).
The X-ray diffraction
The spectrum obtained for XRD of biosynthesized CuNPs is represented in Fig. 3. The size range for particles was detected as 60–80 nm. The peak values are also inconsistent with the joint committee of powder diffraction standards (file no. 089-2838) which further support the formation of crystals of CuNPs.
The scanning electron microscope analysis
The plant CuNPs were analyzed by using Scanning Electron Microscopy which revealed their surface morphology. CuNPs were found in a range of 2 µm as shown in Fig. 4.
Biological activity of copper nanoparticles
Different bacterial species showed different zones of inhibition, which were calculated in terms of their diameter as it was 17 mm for E. coli and 20 mm for B. subtilis (Fig. 5). Tables 1 and 2 show the values of MIC performed for the leaves extract of G. asiatica L. and copper nanoparticles. Table 3 represents a comparative analysis of results from previous studies.
MIC of bacterial species:
In the present study, it was also observed that an increase in the concentration of nanoparticles lead to severe disruption in bacterial cells and the growth of bacteria ceased. The MIC value of G. asiatica L. leaves extract and copper nanoparticles were calculated. The results depicted that copper nanoparticles and aqueous leaves extract of G. asiatica L. show significant inhibitory results against two bacterial pathogens (Tables 1, 2). The minimum inhibitory concentration of copper nanoparticles was 7 mg/ml and 8 mg/ml against B. subtilis and E. coli respectively (Table 2).
The anti-fungal action of CuNPs
In the case of the fungal specie A. oryzae the zone of inhibition was calculated as 23 mm and for A. niger, it was 22 mm (Fig. 6). It is exhibited that CuNPs damage the membrane fungal cells which contain ergosterol that makes distinctive inclinations inside the cytoplasmic membrane. CuNPs damage membrane structure and cause the death of the cell.
The larvicidal action of CuNPs
The CuNPs were tested against hatchlings of A. aegypti and at 100 mg/ml they were found to be most efficient, represented in Figs. 7 and 8, respectively. When the dead larvae were observed under the microscope there were some darkish spots observed, yet the chemical component responsible for this is still unknown. These dark spots were not observed in the untreated larvae kept as control, on the other hand in dead forms these were found to be CuNPs, forming structure groups inside the larvae. Inside the cells i.e., intracellular spaces the CuNPs join with the Sulfur and Phosphorus groups present in proteins and DNA which results in the organelles and chemicals denaturation, and lately these NPs meddle with the process of ATP development causing cell demise.
The anti-termite action of biosynthesized CuNPs
The CuNPs nanoparticles proved to be exceedingly effective against selected termite types. At 100 ppm grouping of CuNPs, a high death rate appeared which can be seen in Figs. 9 and 10. The mortality rate of species was observed every 24 h. The results were interpreted in terms of mean in Table 4. The synthesized nanoparticles are found highly effective against selected species of termite. At 100 ppm concentration of CuNPs highest mortality rate in termites was seen. This is because of the high toxicity of increased concentration of nanoparticles.
Discussion
With the reference to Sect. 3.1.2, the functional groups helped out in the synthesis of CuNps whereas from the literature it is revealed that these chemical components reduced copper ions to nanoparticles and also responsible for their capping and stabilization (Saranyaadevi et al. 2014). Studies revealed that on the surface of nanoparticles, some peak values show the presence of some proteins. Which might be responsible for the CuNPs biosynthesis. Such protein particles can produce a medium responsible for the stability of nanoparticles and responsible for anti-oxidation (Caroling et al. 2015b).
The antibacterial activity of these CuNPs is shown in Fig. 5 which complies with the results from literature where stronger interactions were observed between gram-positive bacteria and nanoparticles than with gram-negative ones (Paul 2015; Jayaseelan et al. 2013; Sap-Iam et al. 2010). Also, it was previously studied that interaction between nanoparticles and gram-positive bacteria is stronger as compared to gram-negative bacteria. This is due to the difference in the composition the of cells wall of gram-negative and gram-positive bacteria. The cell wall of gram-negative bacteria composed of proteins, lipids and lipopolysaccharides, provides excellent protection from biociding agents (Suman et al. 2013). In the previous literature, considerable studies have been reported on the synthesis of nanoparticles and their activity against micro-organisms (Caroling et al. 2015a, 2015b). Also, there is no such prior research done on larvicidal and anti-termite activities.
The MIC prepared from aqueous leaves extract-based CuNPs were found to be highly effective against two different strains of bacteria used in the present studies, the effect on these bacteria was by some past results where it was found that copper nanoparticles interact with the bacterial cell membrane, disrupt it and gain entry inside the cell, due to their large surface area and small size. Inside the cell CuNPs interfere, with enzyme functions by binding the carboxyl and sulfhydryl group of amino acids and destroying the functions of other cells. Outside the bacterial cell, nanoparticles indirectly affect the bacteria by altering the surrounding charge environment (Singh et al. 2016). Other investigations showed that the CuNPs are in cause pits formation on cell surface due to which pores produce and cell death occurs (Sap-Iam et al. 2010). CuNPs were found in rich quantities in the dead Larvae, where the black spots on the dead bodies were found due to the phosphors and the NPs interaction. While it is reported from the literature that the clear mechanism behind the larvicidal activity of nanoparticles is unknown. The possible mechanism is based on the ability of nanoparticles to pass through the cellular membrane, which causes the death of the larva. After a specific time, interval, when the dead larva was observed under a microscope, dark spots were seen inside the body of the larva. These dark spots are probably the nanoparticles that form clusters inside the larval body, as they were not seen in the larva cultured as control. In the intracellular spaces, the copper nanoparticles can bind to phosphorous and sulfur-containing compounds like proteins and DNA which causes denature of some enzymes and organelles. Thereafter, the nanoparticles interfere with the ATP construction process because of cellular function loss and cell death (Suman et al. 2013). At every one-day interval, the increasing concentrations of the CuNPs proved to be even toxic for the termites and the mortality rate enhanced accordingly. The results were compared to the available literature (Sap-Iam et al. 2010).
Conclusions
The present research shows that a green synthesis of metallic nanoparticles is indeed a very useful method because of its economic and environmental aspects. The synthesized CuNPs were characterized by FTIR, XRD and SEM. The particle size of nanoparticles was found in the range of 60–80 nm. The leaves of G. asiatica L. were used as a reducing agent for the synthesis CuNPs. The Copper nanoparticles exhibit significant antibacterial activity against E. coli and B. subtilis, their zone of inhibition was 17 nm and 20 nm, respectively. The antifungal potential was checked against A. niger and A. oryzae and the zone of inhibition was recorded at 20 mm and 23 mm, respectively. CuNPs were also found lethal for many mosquitoes and maximum efficacy of CuNPs against A. aegypti larva was observed at 100 mg/ml after 24 h. Termite species such as H. indicola were with the highest mortality rate at 100 ppm concentration of CuNPs. Current research provides the first investigation of CuNPs of G. asiatica as a larvicidal and as an anti-termite. The survival rate of the species was decreased after treatment with CuNPs. These outcomes recommended that CuNPs can be used as a biological control of different pathogens and vectors.
Availability of data and materials
Data sharing is not applicable to this article as no datasets were generated or analyzed during the current study.
References
Ahmed S, Ahmad M, Swami BL, Ikram S (2016) A review on plants extract mediated synthesis of silver nanoparticles for antimicrobial applications: a green expertise. J Adv Res 7:17–28
Akintelu SA, Oyebamiji AK, Olugbeko SC, Latona DF (2021) Green chemistry approach towards the synthesis of copper nanoparticles and its potential applications as therapeutic agents and environmental control. Curr Opin Green Sustain Chem 4:100176
Angrasan M, Subbaiya R (2014) Biosynthesis of copper nanoparticles by Vitis vinifera leaf aqueous extract and its antibacterial activity. Int J Curr Microbiol App Sci 3(9):768–774
Aziz AM, Khan HM, Adnan M, Izatullah I (2017) Traditional uses of medicinal plants reported by the indigenous communities and local herbal practitioners of Bajaur Agency, Federally Administrated Tribal Areas, Pakistan. J Ethnopharmacol 198:268–281
Caroling G, Vinodhini E, Ranjitham AM, Shanthi P (2015a) Biosynthesis of copper nanoparticles using aqueous Phyllanthus embilica (gooseberry) extract-characterisation and study of antimicrobial effects. Int J Nanomater Chem 1(2):53–63
Caroling G, Vinodhini E, Ranjitham AM, Shanthi P (2015b) Biosynthesis of copper nanoparticles using aqueous Phyllanthus embilica (gooseberry) extract-characterisation and study of antimicrobial effects. Int J Nano Chem 1(2):53–63
Chandrakant KT, Dugasanic SR, Aiyer R, Parkc S, Kulkarni A, Sabharwal S (2013) Green synthesis of silver nanoparticles and their application for the development of optical fiber based hydrogen peroxide sensor. Sens Actuators B 183(3):144–149
Jayandran M, Haneefa MM, Balasubramanian V (2015) Green synthesis of copper nanoparticles using natural reducer and stabilizer and an evaluation of antimicrobial activity. J Chem Pharm Res 7(2):251–259
Jayaseelan C, Rahuman AA, Rajakumar G, Santhoshkumar T, Kirthi AV et al (2012) Efficacy of plant-mediated synthesized silver nanoparticles against hematophagous parasites. J Parasitol Res 111(2):921–933
Jayaseelan C, Ramkumar R, Rahuman AA, Perumal P (2013) Green synthesis of gold nanoparticles using seed aqueous extract of Abelmoschus esculentus and its antifungal activity. Ind Crops Prod 45:423–429
Kaneria M, Baravalia Y, Vaghasiya Y, Chanda S (2009) Determination of antibacterial and antioxidant potential of some medicinal plants from Saurashtra Region, India. Indian J Pharm Sci 71(4):406–412
Karimi J, Mohsenzadeh S (2013) Plant synthesis of silver nanoparticles by Achillea wilhelmsii pharmaceutical plant. Razi J Med Sci 20(111):64–69
Kiranmai M, Kadimcharla K, Keesara NR, Fatima SN, Bommena P, Batchu UR (2017) Green synthesis of stable copper nanoparticles and synergistic activity with antibiotics. Indian J Pharm Sci 79(5):695–700
Mary AA, Ansari AT, Subramanian R (2019) Sugarcane juice mediated synthesis of copper oxide nanoparticles, characterization and their antibacterial activity. J King Saud Univ Sci 31(4):1103–1114
Nagaraj E, Karuppannan K, Shanmugam P, Venugopal S (2019) Exploration of bio-synthesized copper oxide nanoparticles using pterolobium hexapetalum leaf extract by photocatalytic activity and biological evaluations. J Clust Sci 30(4):1157–1168
Paul S (2015) Pharmacological actions and potential uses of Grewia asiatica: a review. Int J Appl Res 1(9):222–228
Ramyadevi J, Jeyasubramanian K, Marikani A, Rajakumar G, Rahuman AA (2012) Synthesis and antimicrobial activity of copper nanoparticles. Mater Lett 71:114–116
Sap-Iam N, Homklincha C, Larpudomle R, Warisnoich W, Sereemaspu A et al (2010) UV irradiation-induced silver nanoparticles as mosquito larvicides. J Appl Sci 10:3132–3136
Saranyaadevi K, Subha V, Ravindran RE, Renganathan S (2014) Synthesis and characterization of copper nanoparticle using Capparis zeylanica leaf extract. Int J Chem Technol Res 6(10):4533–4541
Singh P, Kim YJ, Zhang D, Yang DC (2016) Biological synthesis of nanoparticles from plants and microorganisms. Trends Biotechnol 34(7):588–599
Sinha PS, Chuhan SK, Rai G (2015) Nutritional and medicinal potential of Grewia subinaequalis DC. (syn. G. asiatica) (Phalsa). J Med Plants Res 9(19):594–612
Suman T, Elumalai D, Kaleena P, Rajasree SR (2013) GC–MS analysis of bioactive components and synthesis of silver nanoparticle using Ammannia baccifera aerial extract and its larvicidal activity against malaria and filariasis vectors. Ind Crops Prod 47:239–245
Umer S, Naveed N, Ramzan MS, Rafique M, Imran A (2014) Green method for the synthesis of copper nanoparticles using L-ascorbic acid. Matéria (Rio J) 19(3):197–203
Valli G, Suganya M (2016) Green synthesis of copper nanoparticles using Delonix elata flower extract. Int J Nano Corr Sci Engg 3(4):156–165
Velsankar K, RM AK, Preethi R, Muthulakshmi V, Sudhahar S (2020) Green synthesis of CuO nanoparticles via Allium sativum extract and its characterizations on antimicrobial, antioxidant, antilarvicidal activities. J Environ Chem Eng 8(5):104123
Zhao H, Haitao S, Ahmeda A, Sun Y, Li Z, Zangeneh MM, Nowrozi M, Zangeneh A, Moradi R (2020) Biosynthesis of copper nanoparticles using Allium eriophyllum Boiss leaf aqueous extract; characterization and analysis of their antimicrobial and cutaneous wound‐healing potentials. Appl Organometal Chem. https://doi.org/10.1002/aoc.5587
Zhu HT, Zhang CY, Yin YS (2004) Rapid synthesis of copper nanoparticles by sodium hypophosphite reduction in ethylene glycol under microwave irradiation. J Cryst Growth 270(3):722–728
Zia-Ul-Haq M, Stanković MS, Rizwan K, Feo VD (2013) Grewia asiatica L., a food plant with multiple uses. Molecules 18(3):2663–2682
Zia-Ul-Haq M, Riaz M, De-Feo V, Jaafar HZ, Moga M (2014) Rubus fruticosus L.: constituents, biological activities and health related uses. Molecules 19:10998–11029
Acknowledgements
Not applicable.
Funding
Not applicable.
Author information
Authors and Affiliations
Contributions
Conceptualization and design were performed by Z.J. and J.S.-R.; Experimental study, validation, investigation, data curation, and writing were performed by Y A.T., C.Q., J.H.-B., H.I., Z.ul H., F.A., Z.J., A.S; review and editing were performed by J.S.-R. and Z.J. All the authors read and approved the final manuscript.
Corresponding author
Ethics declarations
Ethics approval and consent to participate
Not applicable.
Consent for publication
Not applicable.
Competing interests
The authors declare that they have no competing interests.
Additional information
Publisher's Note
Springer Nature remains neutral with regard to jurisdictional claims in published maps and institutional affiliations.
Rights and permissions
Open Access This article is licensed under a Creative Commons Attribution 4.0 International License, which permits use, sharing, adaptation, distribution and reproduction in any medium or format, as long as you give appropriate credit to the original author(s) and the source, provide a link to the Creative Commons licence, and indicate if changes were made. The images or other third party material in this article are included in the article's Creative Commons licence, unless indicated otherwise in a credit line to the material. If material is not included in the article's Creative Commons licence and your intended use is not permitted by statutory regulation or exceeds the permitted use, you will need to obtain permission directly from the copyright holder. To view a copy of this licence, visit http://creativecommons.org/licenses/by/4.0/.
About this article
Cite this article
Tahir, A., Quispe, C., Herrera-Bravo, J. et al. Green synthesis, characterization and antibacterial, antifungal, larvicidal and anti-termite activities of copper nanoparticles derived from Grewia asiatica L.. Bull Natl Res Cent 46, 188 (2022). https://doi.org/10.1186/s42269-022-00877-y
Received:
Accepted:
Published:
DOI: https://doi.org/10.1186/s42269-022-00877-y